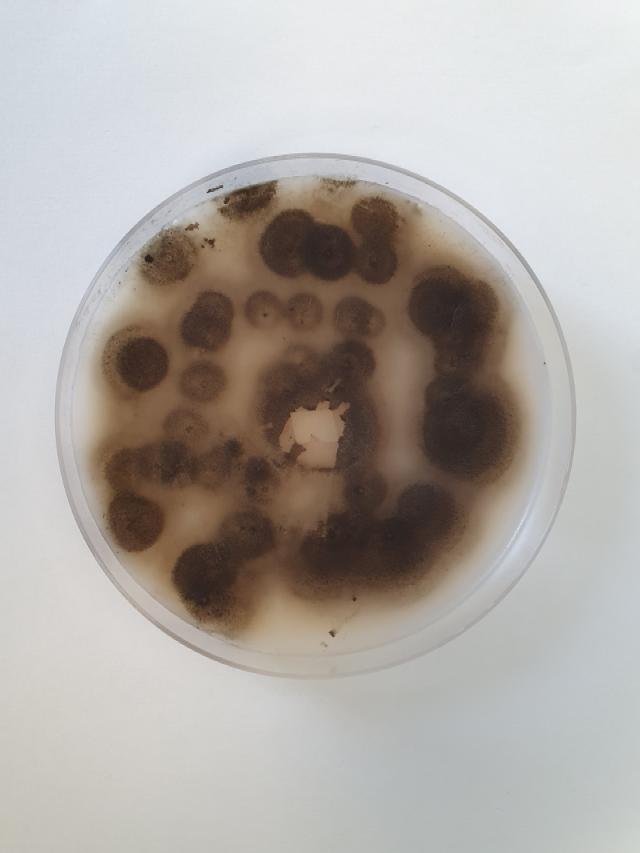

Gray Leaf Spot resistant turf
As climate change brings more hot and humid weather, the severity and geographic range of fungal diseases are increasing. Disease control has become a greater challenge for many turf managers as they seek to reduce pesticide use. Choosing varieties from DLF with high Gray Leaf Spot (GLS) resistance reduces your reliance on fungicides, and gives you a better pitch quality, more playing hours and increased peace of mind.
What is Gray Leaf Spot?
GLS is a turfgrass foliar disease caused by a fungus Pyricularia oryzae. The fungus can attack cool season turfgrasses primarily perennial ryegrass and tall fescue. 4 - 5 weeks old seedlings are extremely susceptible, and a pitch can be destroyed within 3-5 days.
Early symptoms of gray leaf spot begin as small, watersoaked or greasy-looking spots on the leaf blades. These spots typically have an olive green to grayish appearance at first. As the disease progresses, the spots enlarge and develop into tan or light brown lesions with distinct purple, brown, or reddish margins. The shape of these lesions is usually oval, elongated, or irregular. Under humid conditions, a gray, fuzzy growth made up of fungal spores often appears on the surface of the lesions. This gray spore mass is one of the key identifying features of the disease and is the reason for its name, “gray leaf spot.” As the infection becomes more severe, the affected leaves may wither, twist, and eventually die back. On a larger scale, the turfgrass in infected areas will appear thinned, patchy, or scorched, resembling drought or heat damage. In very severe cases, large sections of turf can collapse and die rapidly, especially during periods of hot and humid weather combined with a high amount of fertiliser application.
GLS Screening
Screening for GLS has been performed by CIRAD, an independent research institute in France who has been working with GLS for many years. They used six genetically different genotypes collected on European football stadiums for screening.

.jpg&width=640&format=webp&quality=99)
Gray Leaf Spot problems
GLS is becoming more common in high-end stadiums and training grounds across Southern Europe, but the disease is also registered as causing problems in more northern parts of Europe. The disease can potentially lead to the loss of an entire pitch if it attacks young seedlings during establishment or renovation. It can also have a huge impact on the pitch quality if it occurs later in the season due to hot and moist weather.
Screening results
The results of the screening show significant differences in levels of Gray Leaf Spot resistance between perennial ryegrass varieties. There are varieties in our ryegrass portfolio that are more resistant to GLS than others.
In the graph you can see the relative score of GLS resistance among perennial ryegrasses from DLF.
